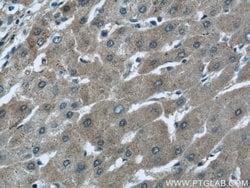
ALDH1A1 Rabbit anti-Human, Mouse, Rat, Polyclonal, Proteintech 20 &mu;L;
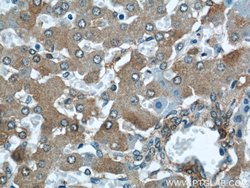
ALDH1A1 Rabbit anti-Human, Mouse, Rat, Polyclonal, Proteintech 20 &mu;L;

missing translation for 'onlineSavingsMsg'
Learn More
Learn More
ALDH1A1 Rabbit anti-Human, Mouse, Rat, Polyclonal, Proteintech
Rabbit Polyclonal Antibody
Brand: Proteintech 22109-1-AP-20UL
This item is not returnable.
View return policy
Description
ALDH1A1 belongs to the aldehyde dehydrogenases family of proteins. Aldehyde dehydrogenase is the second enzyme of the major oxidative pathway of alcohol metabolism. Two major liver isoforms of this enzyme, cytosolic and mitochondrial, can be distinguished by their electrophoretic mobilities, kinetic properties, and subcellular localizations. Most Caucasians have two major isozymes, while approximately 50% of Orientals have only the cytosolic isozyme, missing the mitochondrial isozyme. A remarkably higher frequency of acute alcohol intoxication among Orientals than among Caucasians could be related to the absence of the mitochondrial isozyme.Specifications
| ALDH1A1 | |
| Polyclonal | |
| Unconjugated | |
| ALDH1A1 | |
| ALDC, ALDH E1, ALDH1, ALDH11, ALDH1A1, ALHDII, PUMB1, RALDH 1, RALDH1, Retinal dehydrogenase 1 | |
| Rabbit | |
| Antigen Affinity Chromatography | |
| RUO | |
| 11668, 216, 24188 | |
| -20°C | |
| Liquid |
| Immunocytochemistry, Western Blot, Immunohistochemistry (Paraffin), Immunofluorescence | |
| 0.31 mg/mL | |
| PBS with 50% glycerol and 0.02% sodium azide; pH 7.3 | |
| P00352, P24549, P51647 | |
| ALDH1A1 | |
| ALDH1A1 Fusion Protein Ag17358 | |
| 20 μL | |
| Primary | |
| Human, Mouse, Rat | |
| Antibody | |
| IgG |
Product Content Correction
Your input is important to us. Please complete this form to provide feedback related to the content on this product.
Product Title
Spot an opportunity for improvement?Share a Content Correction